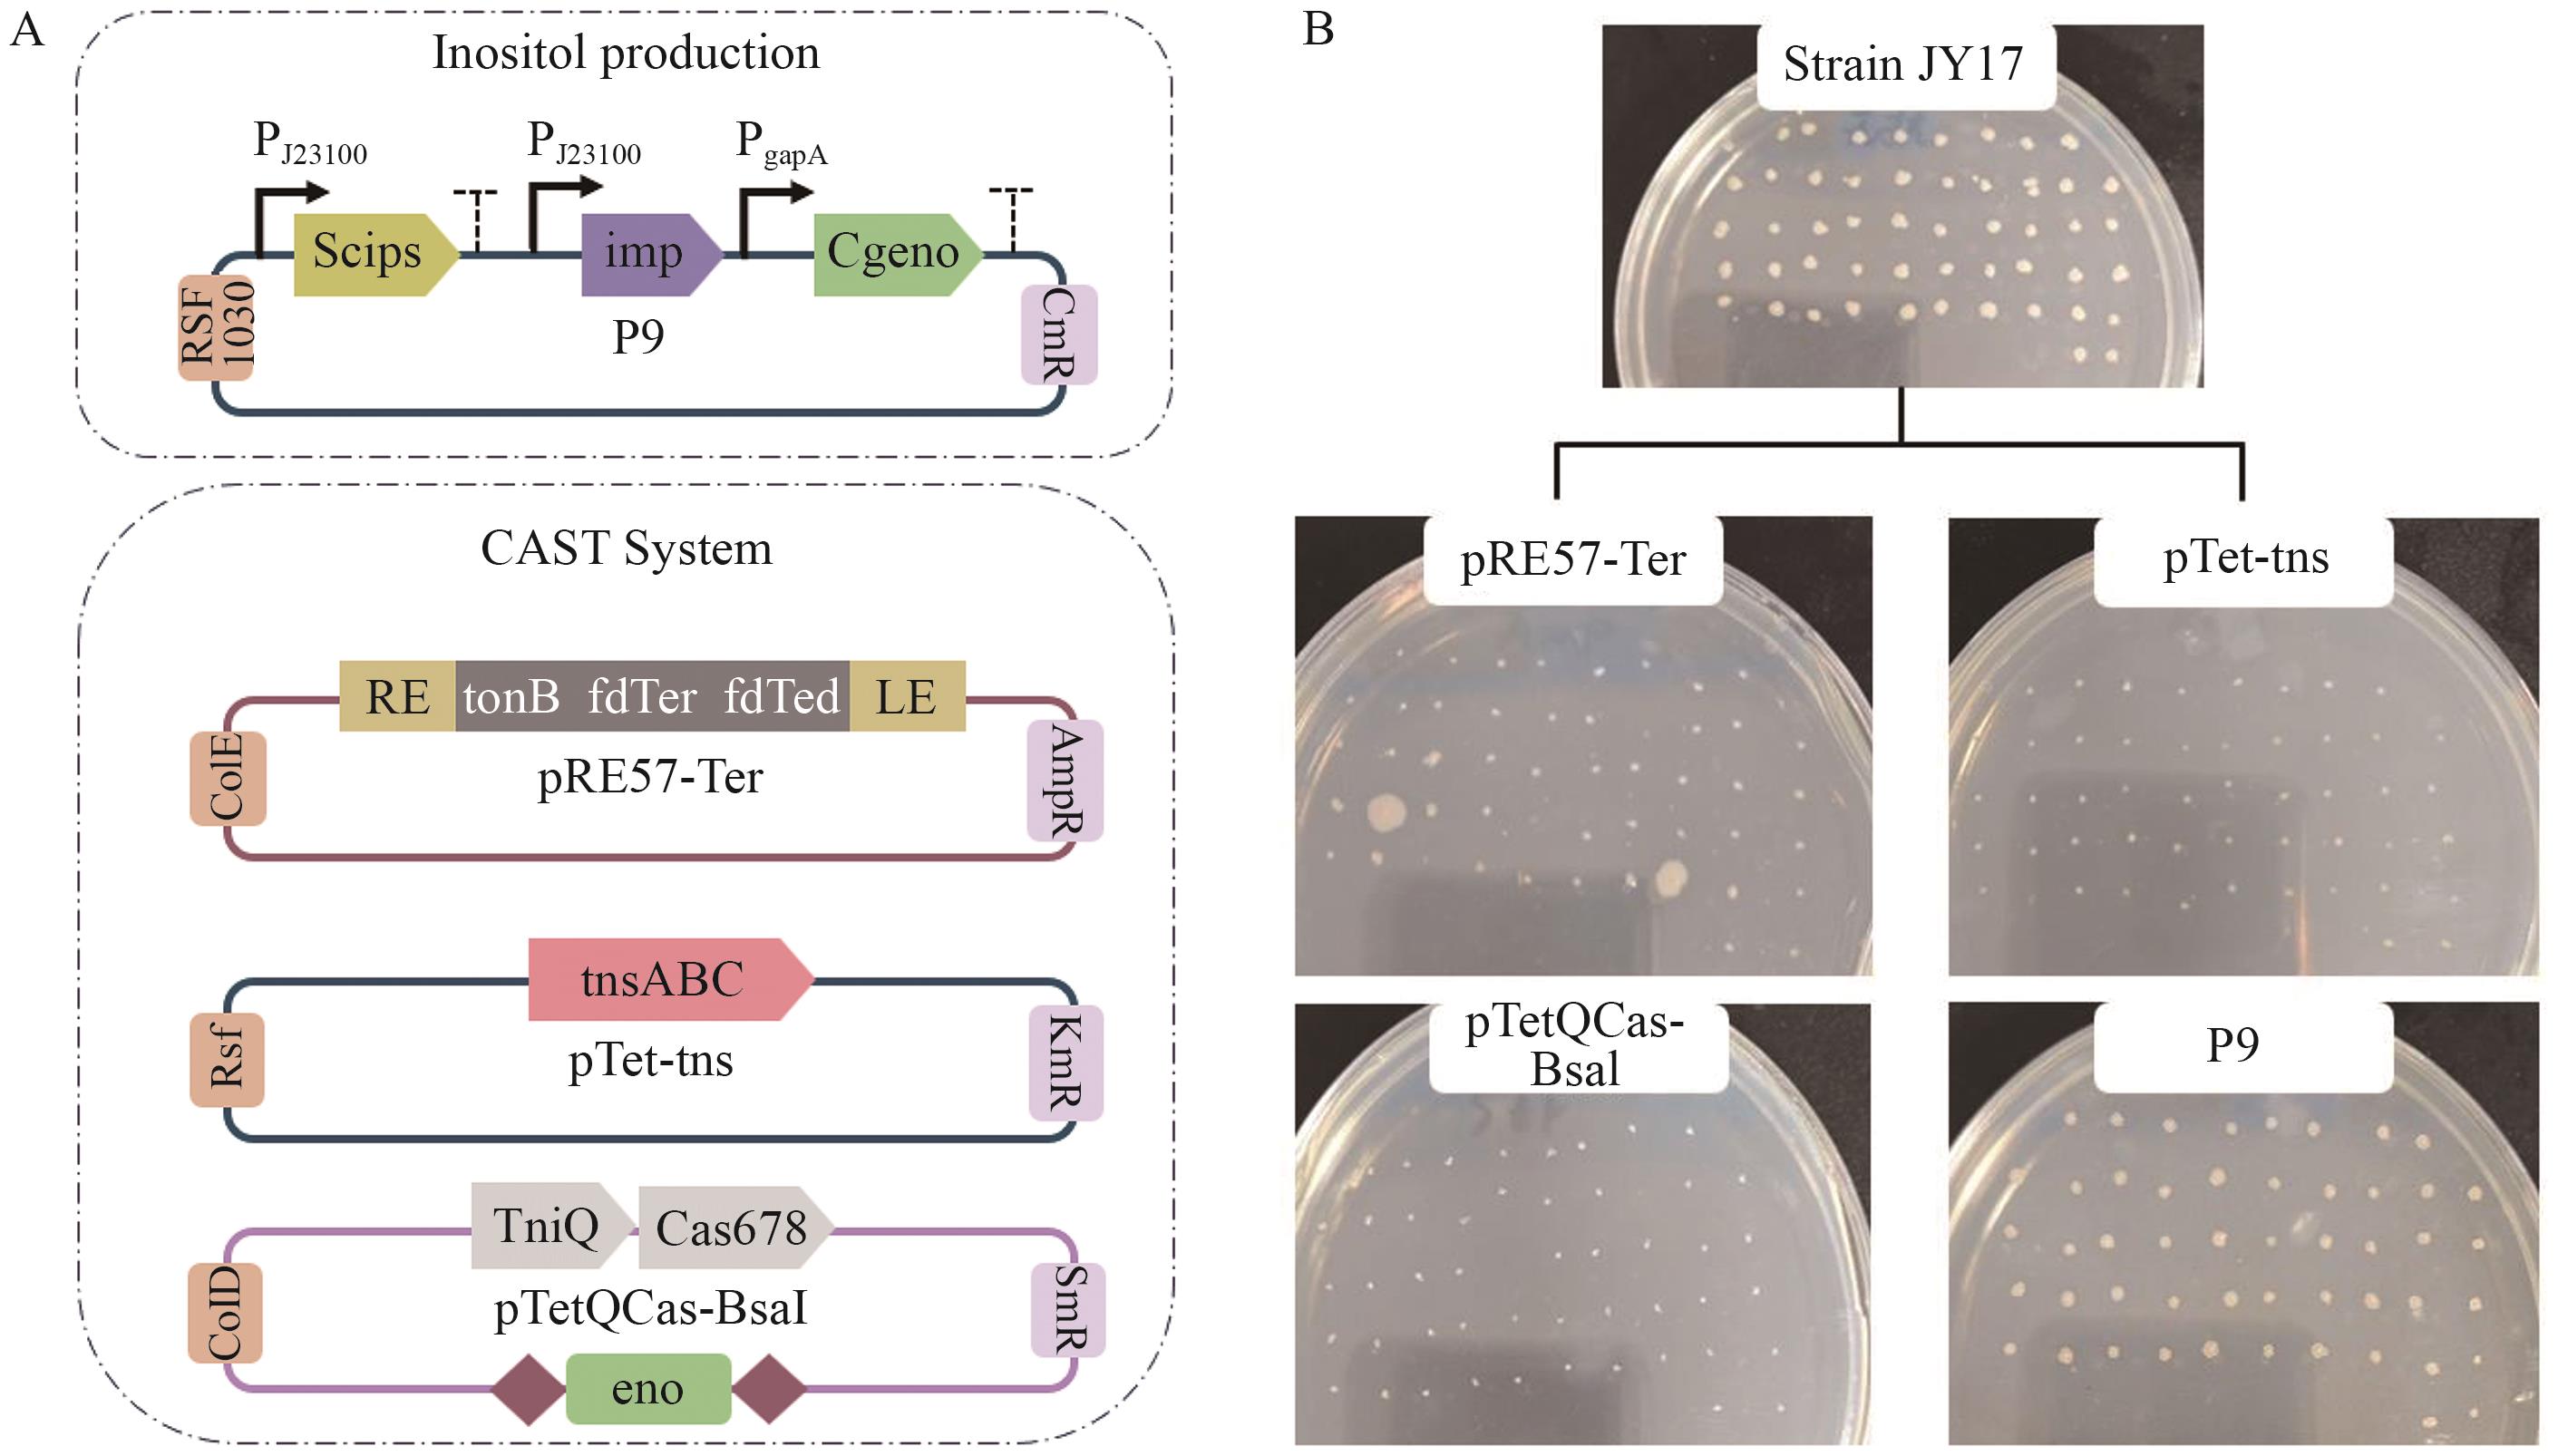

生物技术通报 ›› 2025, Vol. 41 ›› Issue (11): 121-133.doi: 10.13560/j.cnki.biotech.bull.1985.2025-0372
• 未来食品工程专题 • 上一篇
杨熠辰1( ), 朱宏宇2, 苏小运2, 王苑2, 罗会颖2, 田健2, 姚斌1,2, 黄火清2(
), 朱宏宇2, 苏小运2, 王苑2, 罗会颖2, 田健2, 姚斌1,2, 黄火清2( ), 张杰2(
), 张杰2( )
)
收稿日期:2025-04-09
出版日期:2025-11-26
发布日期:2025-12-09
通讯作者:
黄火清,男,博士,研究员,研究方向 :微生物与酶工程;E-mail: huanghuoqing@caas.cn作者简介:杨熠辰,男,硕士研究生,研究方向 :微生物代谢工程;E-mail: xms02yyc@163.com
基金资助:
YANG Yi-chen1( ), ZHU Hong-yu2, SU Xiao-yun2, WANG Yuan2, LUO Hui-ying2, TIAN Jian2, YAO Bin1,2, HUANG Huo-qing2(
), ZHU Hong-yu2, SU Xiao-yun2, WANG Yuan2, LUO Hui-ying2, TIAN Jian2, YAO Bin1,2, HUANG Huo-qing2( ), ZHANG Jie2(
), ZHANG Jie2( )
)
Received:2025-04-09
Published:2025-11-26
Online:2025-12-09
摘要:
目的 改造大肠杆菌的果糖与葡萄糖共代谢系统,建立肌醇合成代谢通路,构建以果葡糖浆为原料高产肌醇的大肠杆菌工程菌株。 方法 以大肠杆菌BW25113为出发菌株,首先通过阻断糖酵解途径和磷酸戊糖途径的关键节点,提高肌醇合成前体6-磷酸葡萄糖的供给,并通过过表达酿酒酵母来源的肌醇-3-磷酸合酶基因(Scips)和大肠杆菌来源的肌醇单磷酸酶基因(imp)引入肌醇合成模块;其次通过基因组整合过表达酿酒酵母来源的景天庚酮糖-1,7-二磷酸酶基因(Scshb17)及果糖转运系统相关基因,构建果糖-葡萄糖共利用体系;最终通过敲除底盘菌株烯醇化酶基因eno,构建肌醇合成模块与eno协同表达载体,实现无抗生素条件下肌醇合成基因的高效稳定表达。 结果 以F42型果葡糖浆为底物进行无抗生素发酵时,最优工程菌JY18的肌醇产量达到40.53 g/L,葡萄糖转化率为0.92 g/g,生产强度为0.64 g/(L·h)。 结论 建立的果糖-葡萄糖共利用系统及肌醇合成模块-eno协同表达系统有效提升了工程菌株的碳源适应性与生产稳定性,为以果葡糖浆为原料的生物炼制平台的建立提供了创新技术方案和理论支撑。
杨熠辰, 朱宏宇, 苏小运, 王苑, 罗会颖, 田健, 姚斌, 黄火清, 张杰. 以果葡糖浆为底物高效合成肌醇细胞工厂的构建[J]. 生物技术通报, 2025, 41(11): 121-133.
YANG Yi-chen, ZHU Hong-yu, SU Xiao-yun, WANG Yuan, LUO Hui-ying, TIAN Jian, YAO Bin, HUANG Huo-qing, ZHANG Jie. Construction of an Efficient Microbial Cell Factory for Inositol Production from Glucose-fructose Syrup[J]. Biotechnology Bulletin, 2025, 41(11): 121-133.

图1 利用果糖和葡萄糖生产肌醇代谢图glf:葡萄糖促扩散蛋白基因;glk:葡萄糖激酶基因;imp:肌醇单磷酸酶基因;Scips:源自酿酒酵母的肌醇-3-磷酸合酶基因; pgi:葡萄糖-6-磷酸异构酶基因;zwf:葡萄糖-6-磷酸脱氢酶基因; tktA:转酮醇酶基因; fucP: 果糖转运蛋白基因;mak:果糖激酶基因;Scshb17:景天庚酮糖双磷酸酶基因;Cgeno:来源于谷氨酸棒杆菌的烯醇化酶基因
Fig. 1 Inositol biosynthesis pathway using fructose and glucose as substrateglf: Glucose facilitator gene. glk: Glucokinase gene. imp: Inositol monophosphatase gene. Scips: Inositol-3-phosphate synthase gene derived from Saccharomyces cerevisiae. pgi: Glucose-6-phosphate isomerase gene. zwf: Glucose-6-phosphate dehydrogenase gene. tktA: Transketolase gene. fucP: Fructose transporter gene. mak: Fructokinase gene. Scshb17: Sedoheptulose bisphosphatase gene. Cgeno: Enolase gene derived from Corynebacterium glutamicum
菌株/质粒 Strains/Plasmids | 相关特性 Relevant characteristics | 来源 Sources |
|---|---|---|
| Strains | ||
| E. coli Trans1-T1 | Commercial host for cloning | TransGen Biotech |
| E. coli BW25113 | Wild type, starting strain | Lab storage |
| JY1 | E. coli BW25113ΔpgiΔzwf | This study |
| JY2 | JY1 harboring plasmid P5 | This study |
| JY3 | JY1ΔgapC1::P gapA -Scshb17 | This study |
| JY4 | JY1ΔP tktA ::P gapA -Scshb17-P J23100 | This study |
| JY5 | JY1ΔS9::P gapA -fucP | This study |
| JY6 | JY3ΔS9::P gapA -fucP | This study |
| JY7 | JY4ΔS9::P gapA -fucP | This study |
| JY8 | JY4ΔP mak ::P gapA -fucP-P J23100 | This study |
| JY9 | JY6 harboring plasmid P5 | This study |
| JY10 | JY7 harboring plasmid P5 | This study |
| JY11 | JY6ΔLafu::P J23100 -imp; ΔydeU:: P J23100 -imp | This study |
| JY12 | JY11ΔycdN::P araBAD -Scips | This study |
| JY13 | JY11ΔycdN::P araBAD -Scips; ΔadhE::P araBAD -Scips | This study |
| JY14 | JY11ΔycdN::P araBAD -Scips; ΔadhE::P araBAD -Scips; ΔycjV::P araBAD -Scips | This study |
| JY15 | JY11ΔyciQ:: P J23100 -Scips | This study |
| JY16 | JY11ΔyciQ:: P J23100 -Scips; Δycgh:: P J23100 -Scips | This study |
| JY17 | JY6Δeno harboring plasmid P9 | This study |
| JY18 | JY6Δeno harboring plasmid P10 | This study |
| Plasmid | ||
| pTetQCas-BsaI | CloDF13 ori, SmR, Ptet-tniQ-cas876, Ptet-CRISPR (containing two BsaI restriction sites) | [ |
| pTet-tns | RSF1030 ori, KanR, Ptet-tnsABC | [ |
| pRE57-Ter | ColE1 ori, AmpR, Donor plasmid harboring Right end (57 bp)-terminator-Left end cassette | [ |
| pEASY-T3 | ColE1 ori, AmpR, TA cloning vector | Lab storage |
| pRSFDuet-1 | KanR, RSF ori, expression vector | Lab storage |
| pETDuet-1 | AmpR, ColE1 ori, expression vector | Lab storage |
| P1 | pEASY-T3 harboring sgRNA2-gapC; P gapA -Scshb17 | This study |
| P2 | pEASY-T3 harboring sgRNA-S9; P gapA -fucP | This study |
| P3 | pEASY-T3 harboring sgRNA-P tktA; P gapA -Scshb17-P J23100 | This study |
| P4 | pEASY-T3 harboring sgRNA-P mak; P gapA -fucp-P J23100 | This study |
| P5 | pRSFDuet-1 harboring P J23100 -Scips; P J23100 -imp | This study |
| P6 | pRE57-Ter harboring P J23100 -imp | This study |
| P7 | pRE57-Ter harboring P araBAD -Scips | This study |
| P8 | pRE57-Ter harboring P J23100 -Scips | This study |
| P9 | pRSFDuet-1 harboring P J23100 -Scips; P J23100 -imp; P gapA -Cgeno; CmR | This study |
| P10 | pRSFDuet-1 harboring P J23100 -Scips; P J23100 -imp; P gapA -Cgeno; P J23100 -glk; P phac1 -glf | This study |
表1 本研究所用的菌株与质粒
Table 1 Strains and plasmids used in this work
菌株/质粒 Strains/Plasmids | 相关特性 Relevant characteristics | 来源 Sources |
|---|---|---|
| Strains | ||
| E. coli Trans1-T1 | Commercial host for cloning | TransGen Biotech |
| E. coli BW25113 | Wild type, starting strain | Lab storage |
| JY1 | E. coli BW25113ΔpgiΔzwf | This study |
| JY2 | JY1 harboring plasmid P5 | This study |
| JY3 | JY1ΔgapC1::P gapA -Scshb17 | This study |
| JY4 | JY1ΔP tktA ::P gapA -Scshb17-P J23100 | This study |
| JY5 | JY1ΔS9::P gapA -fucP | This study |
| JY6 | JY3ΔS9::P gapA -fucP | This study |
| JY7 | JY4ΔS9::P gapA -fucP | This study |
| JY8 | JY4ΔP mak ::P gapA -fucP-P J23100 | This study |
| JY9 | JY6 harboring plasmid P5 | This study |
| JY10 | JY7 harboring plasmid P5 | This study |
| JY11 | JY6ΔLafu::P J23100 -imp; ΔydeU:: P J23100 -imp | This study |
| JY12 | JY11ΔycdN::P araBAD -Scips | This study |
| JY13 | JY11ΔycdN::P araBAD -Scips; ΔadhE::P araBAD -Scips | This study |
| JY14 | JY11ΔycdN::P araBAD -Scips; ΔadhE::P araBAD -Scips; ΔycjV::P araBAD -Scips | This study |
| JY15 | JY11ΔyciQ:: P J23100 -Scips | This study |
| JY16 | JY11ΔyciQ:: P J23100 -Scips; Δycgh:: P J23100 -Scips | This study |
| JY17 | JY6Δeno harboring plasmid P9 | This study |
| JY18 | JY6Δeno harboring plasmid P10 | This study |
| Plasmid | ||
| pTetQCas-BsaI | CloDF13 ori, SmR, Ptet-tniQ-cas876, Ptet-CRISPR (containing two BsaI restriction sites) | [ |
| pTet-tns | RSF1030 ori, KanR, Ptet-tnsABC | [ |
| pRE57-Ter | ColE1 ori, AmpR, Donor plasmid harboring Right end (57 bp)-terminator-Left end cassette | [ |
| pEASY-T3 | ColE1 ori, AmpR, TA cloning vector | Lab storage |
| pRSFDuet-1 | KanR, RSF ori, expression vector | Lab storage |
| pETDuet-1 | AmpR, ColE1 ori, expression vector | Lab storage |
| P1 | pEASY-T3 harboring sgRNA2-gapC; P gapA -Scshb17 | This study |
| P2 | pEASY-T3 harboring sgRNA-S9; P gapA -fucP | This study |
| P3 | pEASY-T3 harboring sgRNA-P tktA; P gapA -Scshb17-P J23100 | This study |
| P4 | pEASY-T3 harboring sgRNA-P mak; P gapA -fucp-P J23100 | This study |
| P5 | pRSFDuet-1 harboring P J23100 -Scips; P J23100 -imp | This study |
| P6 | pRE57-Ter harboring P J23100 -imp | This study |
| P7 | pRE57-Ter harboring P araBAD -Scips | This study |
| P8 | pRE57-Ter harboring P J23100 -Scips | This study |
| P9 | pRSFDuet-1 harboring P J23100 -Scips; P J23100 -imp; P gapA -Cgeno; CmR | This study |
| P10 | pRSFDuet-1 harboring P J23100 -Scips; P J23100 -imp; P gapA -Cgeno; P J23100 -glk; P phac1 -glf | This study |
引物名称 Primer name | 引物序列 Primer sequence (5′-3′) |
|---|---|
| gapC2-up-F | CACTAGTGAATTCGCGGCCGCCTGCAGAACAGGAGATAAATCACCAAATGTCCCAAATGCGC |
| gapC2-up-R | AGAGCTCTCCCATATGGTCGACATAAGTGAATCTTCCGTAAAATCAACGC |
| gapC2-down-F | TCGACCATATGGGAGAGCTCTTTACGCCGAAAAAGAGGCTAAAAATATTC |
| gapC2-down-R | AATACTCAAGCTATGCATCCAACGCGTTGGGTTTGCGTGGCATCAAACACCGAACCG |
| gRNA2-gapC-F | TTGACAGCTAGCTCAGTCCTAGGTATAATGCTAGCCGTTGATGGGAAAAGTATCGGTTTTAGAGCTAGAAATAGCAAGTT |
| gRNA2-gapC-R | GGTTCTTATGGCTCTTGTATCTATCAGTGAAGCATCAAGAC |
| S9-up-F | CACTAGTGAATTCGCGGCCGCCTGCAGGCACGGAGAATGGCAGGAAGCATC |
| S9-up-R | CAATCCTACCGAGCTCTCCCATATGGTCGACCAGGTTTATTATATCGCGTTGATTATTGATGCTGTTTTTAGTTTTAACGGC |
| S9-down-F | TAATAAACCTGGTCGACCATATGGGAGAGCTCGGTAGGATTGAAAACGCTCTCCTGATTTTCCAATTCA |
| S9-down-R | GCTATGCATCCAACGCGTTGGGCAGCCCGCCCGGTTGCCCG |
| gRNA-S9-F | TTGACAGCTAGCTCAGTCCTAGGTATAATGCTAGCTCTGGCGCAGTTGATATGTAGTTTTAGAGCTAGAAATAGCAAGTT |
| gRNA-S9-R | GGTTCTTATGGCTCTTGTATCTATCAGTGAAGCATCAAGAC |
| gapA-Scshb17-F | ACGGAAGATTCACTTATGTCGACATCTCGACGAAATGGCTGCAC |
| gapA-Scshb17-R | CATCTGGGGGTTAGCGAAGGCATATATTCCACCAGCTATTTGTTAGTG |
| Scshb17-F | CACTAACAAATAGCTGGTGGAATATATGCCTTCGCTAACCCCCAG |
| Scshb17-R | TTAGCCTCTTTTTCGGCGTAAAGAGCTCTTACACATCGCCATGCTGGG |
| GapA-fucP-F | CAATAATCAACGCGATATAATAAACCTGATCTCGACGAAATGGCTGCAC |
| GapA-fucP-R | GTTTGTATTGATGTGTTTCCCATATATTCCACCAGCTATTTGTTAG |
| fucP-F | ACAAATAGCTGGTGGAATATATGGGAAACACATCAATACAAACGC |
| fucP-R | CAGGAGAGCGTTTTCAATCCTACCGAGCTCCATGGATCCTCAGTTAGTTGCCGTTTGAGAACG |
| gRNA1-gapC-F | TTGACAGCTAGCTCAGTCCTAGGTATAATGCTAGCCGATTTACAACTGGTGAAAAGTTTTAGAGCTAGAAATAGCAAGTT |
| gRNA1-gapC-R | GGTTCTTATGGCTCTTGTATCTATCAGTGAAGCATCAAGAC |
| gapC1-up-F | CACTAGTGAATTCGCGGCCGCCTGCAGCTAAAAATATTCCGTGGAAAGCGAAAGGTGCAGAAAT |
| gapC1-up-R | CCATATTCGTTATCGTACCAGGCGAGAGCTCTCCCATATGGTCGACCCCACGGCGGTAATTTCCGTTTGC |
| gapC1-down-F | CGGAAATTACCGCCGTGGGGTCGACCATATGGGAGAGCTCTCGCCTGGTACGATAACGAATATGGCTTCG |
| gapC1-down-R | CTCAAGCTATGCATCCAACGCGTTGGTTTATGATCAGTTCGTCAATCGGCTGGGTGAAGC |
| phac1+glf-F | GAGCTCTAGCTGGACGTCTAGAGTTGACAGCGCGTGCGTTGCAAG |
| Glf-R | GCCATATTCGTTATCGTACCAGGCGATTATTTCTGGCTGCGCCACATTTC |
| gRNA-P glk -F | TTGACAGCTAGCTCAGTCCTAGGTATAATGCTAGCTCTCACACTGTAAATACCTGGTTTTAGAGCTAGAAATAGCAAGTT |
| gRNA-P glk -R | GGTTCTTATGGCTCTTGTATCTATCAGTGAAGCATCAAGAC |
| glk-up-F | ATTCGCGGCCGCCTGCAGGTCGACCTATTCGGCGCAAAATCAACGT |
| glk-up-R | GAAAGAGGAGAAATACTAGATGACAAAGTATGCATTAGTCGGTGATGTGGGC |
| glk-down-F | CTTTGTCATCATATGACGGAGCTCAGGCAGGCTCCCTGTAAATATC |
| glk-down-R | CAAGCTATGCATCCAACGCGTTGGCGGTCATGATCGGATGTTCCG |
| gRNA-P tktA -F | TTGACAGCTAGCTCAGTCCTAGGTATAATGCTAGCGATCGGATGATGAAGGGCACGTTTTAGAGCTAGAAATAGCAAGTT |
| gRNA-P tktA -R | GGTTCTTATGGCTCTTGTATCTATCAGTGAAGCATCAAGAC |
| gapA-eno-F | CATTTGAGAAGCACACGGTCACACTGCATCTCGACGAAATGGCTGCAC |
| gapA-eno-R | ACGTGCATGATTTCAGCCATATATTCCACCAGCTATTTGTTAGTGAATAAAAG |
| Cgeno-F | CACTAACAAATAGCTGGTGGAATATATGGCTGAAATCATGCACGTATTC |
| Cgeno-R | GTGCGTCGGGTGATGCTGCCAACTTACTTAGCCCTGAAAGCGTGGGAATG |
| CmR-F | GTATCCGCTCATGAATTAATTCCAATAAACCGGTAAACCAGCAATAG |
| CmR-R | GCATTCCCACGCTTTCAGGGCTAAGTAAGTTGGCAGCATCACCCG |
| Scips-F | GAAAGAGGAGAAATACTAGATGACAGAAGATAATATTGCTCCAATCAC |
| imp-R | GACCGTGTGCTTCTCAAATGTTAACGCTTCAGAGCGTCGC |
| P tktA -gRNA | GATCGGATGATGAAGGGCAC |
| pgi-gRNA | TGGCAGGCACTACAGAAACACTTCGATGAAAT |
| zwf-gRNA | GAGACGGCTGAATGCAGCAGTGTCATTGACAT |
| gapC1-gRNA | CGATTTACAACTGGTGAAAA |
| gapC2-gRNA | CGTTGATGGGAAAAGTATCG |
| S9-gRNA | TCTGGCGCAGTTGATATGTA |
| P glk -gRNA | TCTCACACTGTAAATACCTG |
| P mak -gNRA | TAAATCGATACCTATACGCA |
| Cgeno-gRNA | AGGAAGTGAGTGAATTCTTCAGAGGTGAACGC |
| Lafu-gRNA | AAGCTCGGTGGCGGATTTCTTCTTCAGCAGCG |
| ydeU-gRNA | TGGTTGGCTGGTATGGCACTGGAGTGCTTAAT |
| ycdN-gRNA | GTTTCTCATTATGTTGCGCGAAGGACTTGAAG |
| adhE-gRNA | GGCATGGGTATCGTCGAAGATAAAGTGATCAA |
| ycjV-gRNA | GGGCTTGAGGAGATCAGCGGCGGCGATCTGTT |
| ycgh-gRNA | TTCAGATAAGGTGATGCAAGGATTGCAGCTGG |
| yciQ-gRNA | TGGTTTGTGGATGGTTATATCTCTGGAAGCGC |
表2 文中所用的引物及gRNA
Table 2 Primers and gRNA used in this work
引物名称 Primer name | 引物序列 Primer sequence (5′-3′) |
|---|---|
| gapC2-up-F | CACTAGTGAATTCGCGGCCGCCTGCAGAACAGGAGATAAATCACCAAATGTCCCAAATGCGC |
| gapC2-up-R | AGAGCTCTCCCATATGGTCGACATAAGTGAATCTTCCGTAAAATCAACGC |
| gapC2-down-F | TCGACCATATGGGAGAGCTCTTTACGCCGAAAAAGAGGCTAAAAATATTC |
| gapC2-down-R | AATACTCAAGCTATGCATCCAACGCGTTGGGTTTGCGTGGCATCAAACACCGAACCG |
| gRNA2-gapC-F | TTGACAGCTAGCTCAGTCCTAGGTATAATGCTAGCCGTTGATGGGAAAAGTATCGGTTTTAGAGCTAGAAATAGCAAGTT |
| gRNA2-gapC-R | GGTTCTTATGGCTCTTGTATCTATCAGTGAAGCATCAAGAC |
| S9-up-F | CACTAGTGAATTCGCGGCCGCCTGCAGGCACGGAGAATGGCAGGAAGCATC |
| S9-up-R | CAATCCTACCGAGCTCTCCCATATGGTCGACCAGGTTTATTATATCGCGTTGATTATTGATGCTGTTTTTAGTTTTAACGGC |
| S9-down-F | TAATAAACCTGGTCGACCATATGGGAGAGCTCGGTAGGATTGAAAACGCTCTCCTGATTTTCCAATTCA |
| S9-down-R | GCTATGCATCCAACGCGTTGGGCAGCCCGCCCGGTTGCCCG |
| gRNA-S9-F | TTGACAGCTAGCTCAGTCCTAGGTATAATGCTAGCTCTGGCGCAGTTGATATGTAGTTTTAGAGCTAGAAATAGCAAGTT |
| gRNA-S9-R | GGTTCTTATGGCTCTTGTATCTATCAGTGAAGCATCAAGAC |
| gapA-Scshb17-F | ACGGAAGATTCACTTATGTCGACATCTCGACGAAATGGCTGCAC |
| gapA-Scshb17-R | CATCTGGGGGTTAGCGAAGGCATATATTCCACCAGCTATTTGTTAGTG |
| Scshb17-F | CACTAACAAATAGCTGGTGGAATATATGCCTTCGCTAACCCCCAG |
| Scshb17-R | TTAGCCTCTTTTTCGGCGTAAAGAGCTCTTACACATCGCCATGCTGGG |
| GapA-fucP-F | CAATAATCAACGCGATATAATAAACCTGATCTCGACGAAATGGCTGCAC |
| GapA-fucP-R | GTTTGTATTGATGTGTTTCCCATATATTCCACCAGCTATTTGTTAG |
| fucP-F | ACAAATAGCTGGTGGAATATATGGGAAACACATCAATACAAACGC |
| fucP-R | CAGGAGAGCGTTTTCAATCCTACCGAGCTCCATGGATCCTCAGTTAGTTGCCGTTTGAGAACG |
| gRNA1-gapC-F | TTGACAGCTAGCTCAGTCCTAGGTATAATGCTAGCCGATTTACAACTGGTGAAAAGTTTTAGAGCTAGAAATAGCAAGTT |
| gRNA1-gapC-R | GGTTCTTATGGCTCTTGTATCTATCAGTGAAGCATCAAGAC |
| gapC1-up-F | CACTAGTGAATTCGCGGCCGCCTGCAGCTAAAAATATTCCGTGGAAAGCGAAAGGTGCAGAAAT |
| gapC1-up-R | CCATATTCGTTATCGTACCAGGCGAGAGCTCTCCCATATGGTCGACCCCACGGCGGTAATTTCCGTTTGC |
| gapC1-down-F | CGGAAATTACCGCCGTGGGGTCGACCATATGGGAGAGCTCTCGCCTGGTACGATAACGAATATGGCTTCG |
| gapC1-down-R | CTCAAGCTATGCATCCAACGCGTTGGTTTATGATCAGTTCGTCAATCGGCTGGGTGAAGC |
| phac1+glf-F | GAGCTCTAGCTGGACGTCTAGAGTTGACAGCGCGTGCGTTGCAAG |
| Glf-R | GCCATATTCGTTATCGTACCAGGCGATTATTTCTGGCTGCGCCACATTTC |
| gRNA-P glk -F | TTGACAGCTAGCTCAGTCCTAGGTATAATGCTAGCTCTCACACTGTAAATACCTGGTTTTAGAGCTAGAAATAGCAAGTT |
| gRNA-P glk -R | GGTTCTTATGGCTCTTGTATCTATCAGTGAAGCATCAAGAC |
| glk-up-F | ATTCGCGGCCGCCTGCAGGTCGACCTATTCGGCGCAAAATCAACGT |
| glk-up-R | GAAAGAGGAGAAATACTAGATGACAAAGTATGCATTAGTCGGTGATGTGGGC |
| glk-down-F | CTTTGTCATCATATGACGGAGCTCAGGCAGGCTCCCTGTAAATATC |
| glk-down-R | CAAGCTATGCATCCAACGCGTTGGCGGTCATGATCGGATGTTCCG |
| gRNA-P tktA -F | TTGACAGCTAGCTCAGTCCTAGGTATAATGCTAGCGATCGGATGATGAAGGGCACGTTTTAGAGCTAGAAATAGCAAGTT |
| gRNA-P tktA -R | GGTTCTTATGGCTCTTGTATCTATCAGTGAAGCATCAAGAC |
| gapA-eno-F | CATTTGAGAAGCACACGGTCACACTGCATCTCGACGAAATGGCTGCAC |
| gapA-eno-R | ACGTGCATGATTTCAGCCATATATTCCACCAGCTATTTGTTAGTGAATAAAAG |
| Cgeno-F | CACTAACAAATAGCTGGTGGAATATATGGCTGAAATCATGCACGTATTC |
| Cgeno-R | GTGCGTCGGGTGATGCTGCCAACTTACTTAGCCCTGAAAGCGTGGGAATG |
| CmR-F | GTATCCGCTCATGAATTAATTCCAATAAACCGGTAAACCAGCAATAG |
| CmR-R | GCATTCCCACGCTTTCAGGGCTAAGTAAGTTGGCAGCATCACCCG |
| Scips-F | GAAAGAGGAGAAATACTAGATGACAGAAGATAATATTGCTCCAATCAC |
| imp-R | GACCGTGTGCTTCTCAAATGTTAACGCTTCAGAGCGTCGC |
| P tktA -gRNA | GATCGGATGATGAAGGGCAC |
| pgi-gRNA | TGGCAGGCACTACAGAAACACTTCGATGAAAT |
| zwf-gRNA | GAGACGGCTGAATGCAGCAGTGTCATTGACAT |
| gapC1-gRNA | CGATTTACAACTGGTGAAAA |
| gapC2-gRNA | CGTTGATGGGAAAAGTATCG |
| S9-gRNA | TCTGGCGCAGTTGATATGTA |
| P glk -gRNA | TCTCACACTGTAAATACCTG |
| P mak -gNRA | TAAATCGATACCTATACGCA |
| Cgeno-gRNA | AGGAAGTGAGTGAATTCTTCAGAGGTGAACGC |
| Lafu-gRNA | AAGCTCGGTGGCGGATTTCTTCTTCAGCAGCG |
| ydeU-gRNA | TGGTTGGCTGGTATGGCACTGGAGTGCTTAAT |
| ycdN-gRNA | GTTTCTCATTATGTTGCGCGAAGGACTTGAAG |
| adhE-gRNA | GGCATGGGTATCGTCGAAGATAAAGTGATCAA |
| ycjV-gRNA | GGGCTTGAGGAGATCAGCGGCGGCGATCTGTT |
| ycgh-gRNA | TTCAGATAAGGTGATGCAAGGATTGCAGCTGG |
| yciQ-gRNA | TGGTTTGTGGATGGTTATATCTCTGGAAGCGC |

图2 重组菌株JY1和JY2的表型验证A:JY1菌株利用不同碳源的生长曲线,10G:发酵培养基含有10.0 g/L葡萄糖;10F:发酵培养基含有10.0 g/L果糖;5G5F:发酵培养基含有5.0 g/L葡萄糖和5.0 g/L果糖。B:JY2菌株在混合碳源中的生长曲线及肌醇产量
Fig. 2 Phenotype verification of recombinant strain JY1 and JY2A: Growth curves of JY1 strain cultured in the medium containing different carbon sources. 10G: Fermentation medium contains 10.0 g/L glucose. 10F: Fermentation medium contains 10.0 g/L fructose. 5G5F: Fermentation medium contains 5.0 g/L glucose and 5.0 g/L fructose. B: Growth curve and inositol production of JY2 strain cultured in the medium containing mixed carbon source

图3 重组菌株JY3-JY10的表型验证A:菌株在混合碳源培养基中的生长曲线;B:菌株在混合碳源培养基中的肌醇产量、碳源残余量及最高OD600
Fig. 3 Phenotype verification of recombinant strain JY3-JY10A: Growth curves of recombinant strains cultured in the medium containing mixed carbon source. B: Inositol production, carbon source concentration and maximum OD600 of recombinant strains cultured in the medium containing mixed carbon source

图4 重组菌株JY12-JY14的3 L反应器发酵结果A:JY12 菌株3 L反应器发酵结果;B:JY13菌株3 L反应器发酵结果;C:JY14菌株3 L反应器发酵结果
Fig. 4 Fermentation results of recombinant strains JY12-JY14 in 3 L reactorA: Fermentation results of JY12 strain in 3 L reactor. B: Fermentation results of JY13 strain in 3 L reactor. C: Fermentation results of JY14 strain in 3 L reactor
图5 Scips、imp和eno基因协同表达系统的建立及稳定性评价A:P9质粒图谱及CAST系统;B:基因编辑及P9表达质粒的稳定性验证
Fig. 5 Establishment and stability evaluation of Scips, imp and eno synergetic expression systemA: P9 plasmid map and CAST system. B: Stability verification of gene editing and P9 expression plasmids

图6 重组菌株JY17的摇瓶发酵结果A:不添加抗生素发酵时生长曲线和肌醇产量;B:不添加抗生素发酵时葡萄糖和果糖消耗;C:添加抗生素发酵时生长曲线和肌醇产量;D:添加抗生素发酵时葡萄糖和果糖消耗
Fig. 6 Shake flask fermentation results of recombinant strain JY17A: Growth curve and inositol production during fermentation without adding antibiotics. B: Glucose and fructose consumption during fermentation without adding antibiotic. C: Growth curve and inositol production during fermentation with adding antibiotic. D: Glucose and fructose consumption during fermentation with adding antibiotic

图7 重组菌株JY17和JY18在3 L反应器中的发酵结果A:JY17的生长曲线和肌醇产量;B:JY17的葡萄糖和果糖消耗;C:JY18的生长曲线和肌醇产量;D:JY18菌株的葡萄糖和果糖消耗
Fig. 7 Fermentated results of recombinant strain JY17 and JY18 in 3 L reactorA: Growth curve and inositol production of JY17. B: Glucose and fructose consumption of JY17. C: Growth curve and inositol production of JY18. D: Glucose and fructose consumption of JY18
| [1] | Murthy PPN. Structure and nomenclature of inositol phosphates, phosphoinositides, and glycosylphosphatidylinositols [J]. Subcell Biochem, 2006, 39: 1-19. |
| [2] | Sinclair KD, Allegrucci C, Singh R, et al. DNA methylation, insulin resistance, and blood pressure in offspring determined by maternal periconceptional B vitamin and methionine status [J]. Proc Natl Acad Sci USA, 2007, 104(49): 19351-19356. |
| [3] | 张泽生, 董硕, 高云峰, 等. 肌醇、D-手性肌醇对大鼠酒精性脂肪肝作用的研究 [J]. 中国食品添加剂, 2014, 25(9): 85-90. |
| Zhang ZS, Dong S, Gao YF, et al. Effect of inositol and D-chiro-inositol on alcoholic fatty liver rats [J]. China Food Addit, 2014, 25(9): 85-90. | |
| [4] | Druzijanic A, Kovic M, Roguljic M, et al. Application of inositol hexaphosphate and inositol in dental medicine: an overview [J]. Biomolecules, 2023, 13(6): 913. |
| [5] | Özturan A, Arslan S, Kocaadam B, et al. Effect of inositol and its derivatives on diabetes: a systematic review [J]. Crit Rev Food Sci Nutr, 2019, 59(7): 1124-1136. |
| [6] | Etrusco A, Laganà AS, Chiantera V, et al. Myo-inositol in assisted reproductive technology from bench to bedside [J]. Trends Endocrinol Metab, 2024, 35(1): 74-83. |
| [7] | Sharma N, Watkins OC, Chu AHY, et al. Myo-inositol: a potential prophylaxis against premature onset of labour and preterm birth [J]. Nutr Res Rev, 2023, 36(1): 60-68. |
| [8] | Heimark D, McAllister J, Larner J. Decreased myo-inositol to chiro-inositol (M/C) ratios and increased M/C epimerase activity in PCOS theca cells demonstrate increased insulin sensitivity compared to controls [J]. Endocr J, 2014, 61(2): 111-117. |
| [9] | López-Gambero AJ, Sanjuan C, Serrano-Castro PJ, et al. The biomedical uses of inositols: a nutraceutical approach to metabolic dysfunction in aging and neurodegenerative diseases [J]. Biomedicines, 2020, 8(9): 295. |
| [10] | Michell RH. Do inositol supplements enhance phosphatidylinositol supply and thus support endoplasmic reticulum function? [J]. Br J Nutr, 2018, 120(3): 301-316. |
| [11] | Gupta A, Sanwal N, Bareen MA, et al. Trends in functional beverages: Functional ingredients, processing technologies, stability, health benefits, and consumer perspective [J]. Food Res Int, 2023, 170: 113046. |
| [12] | Yan EF, Sun HJ, He LJ, et al. Dietary inositol supplementation improves meat quality by modulating amino acid metabolism and gut microbiota composition of finishing pigs [J]. Anim Nutr, 2024, 19: 180-191. |
| [13] | Shiau SY, Su SL. Dietary inositol requirement for juvenile grass shrimp, Penaeus monodon [J]. Aquaculture, 2004, 241(1-4): 1-8. |
| [14] | Rodrigues EJD, de Carvalho PLPF, Silva VF, et al. Myo-inositol increases respiratory burst, cellular proliferation, and phagocytosis of cultured leukocytes from Nile Tilapia [J]. Comp Immunol Rep, 2025, 8: 200193. |
| [15] | Li B, Pan SM, Huang WB, et al. The positive effects of dietary inositol on juvenile hybrid grouper (♀Epinephelus fuscoguttatus × ♂ Epinephelus lanceolatu) fed high-lipid diets: Growth performance, intestinal digestive enzymes, tissue morphology, and intestinal microbiota [J]. Aquac Rep, 2024, 39: 102534. |
| [16] | Michael FR, Koshio S. Biochemical studies on the interactive effects of dietary choline and inositol in juvenile Kuruma shrimp, Marsupenaeus japonicus Bate [J]. Aquaculture, 2008, 285(1-4): 179-183. |
| [17] | Febles CI, Arias A, Hardisson A, et al. Phytic acid level in wheat flours [J]. J Cereal Sci, 2002, 36(1): 19-23. |
| [18] | 黄贞杰, 陈由强, 陈丽霞, 等. 代谢工程改造酿酒酵母合成肌醇 [J]. 微生物学通报, 2017, 44(10): 2289-2296. |
| Huang ZJ, Chen YQ, Chen LX, et al. Metabolic engineering of Saccharomyces cerevisiae for inositol production [J]. Microbiol China, 2017, 44(10): 2289-2296. | |
| [19] | Zhang QQ, Wang XL, Luo HY, et al. Metabolic engineering of Pichia pastoris for myo-inositol production by dynamic regulation of central metabolism [J]. Microb Cell Fact, 2022, 21(1): 112. |
| [20] | You R, Wang L, Shi CR, et al. Efficient production of myo-inositol in Escherichia coli through metabolic engineering [J]. Microb Cell Fact, 2020, 19(1): 109. |
| [21] | 邹世能. 甘油生产的状况和未来 [J]. 日用化学工业, 1996, 26(3): 36-38. |
| Zou SN. Present situation and future of glycerol production [J]. China Surfactant Deterg Cosmet, 1996, 26(3): 36-38. | |
| [22] | Khanna S, Goyal A, Moholkar VS. Microbial conversion of glycerol: present status and future prospects [J]. Crit Rev Biotechnol, 2012, 32(3): 235-262. |
| [23] | Kuznetsova E, Xu LD, Singer A, et al. Structure and activity of the metal-independent fructose-1, 6-bisphosphatase YK23 from Saccharomyces cerevisiae [J]. J Biol Chem, 2010, 285(27): 21049-21059. |
| [24] | Hellgren J, Godina A, Nielsen J, et al. Promiscuous phosphoketolase and metabolic rewiring enables novel non-oxidative glycolysis in yeast for high-yield production of acetyl-CoA derived products [J]. Metab Eng, 2020, 62: 150-160. |
| [25] | Zhang YW, Yang JW, Yang SQ, et al. Programming cells by multicopy chromosomal integration using CRISPR-associated transposases [J]. CRISPR J, 2021, 4(3): 350-359. |
| [26] | Li Q, Sun BB, Chen J, et al. A modified pCas/pTargetF system for CRISPR-Cas9-assisted genome editing in Escherichia coli [J]. Acta Biochim Biophys Sin, 2021, 53(5): 620-627. |
| [27] | Shiue E, Brockman IM, Prather KLJ. Improving product yields on D-glucose in Escherichia coli via knockout of pgi and zwf and feeding of supplemental carbon sources [J]. Biotechnol Bioeng, 2015, 112(3): 579-587. |
| [28] | Li YJ, Han PP, Wang J, et al. Production of myo-inositol: recent advance and prospective [J]. Biotechnol Appl Biochem, 2022, 69(3): 1101-1111. |
| [29] | Li BB, Wang X, Tai L, et al. NAD kinases: metabolic targets controlling redox co-enzymes and reducing power partitioning in plant stress and development [J]. Front Plant Sci, 2018, 9: 379. |
| [30] | Kornberg H, Lourenco C. A route for fructose utilization by Escherichia coli involving the fucose regulon [J]. Proc Natl Acad Sci USA, 2006, 103(51): 19496-19499. |
| [31] | Ji H, Wang JF, Guo JR, et al. Progress in the biological function of alpha-enolase [J]. Anim Nutr, 2016, 2(1): 12-17. |
| [32] | Usui Y, Hirasawa T, Furusawa C, et al. Investigating the effects of perturbations to pgi and eno gene expression on central carbon metabolism in Escherichia coli using 13C metabolic flux analysis [J]. Microb Cell Fact, 2012, 11: 87. |
| [1] | 闫梦阳, 梁晓阳, 戴君昂, 张妍, 关团, 张辉, 刘良波, 孙志华. 阿莫西林降解菌的筛选及降解机制研究[J]. 生物技术通报, 2025, 41(9): 314-325. |
| [2] | 黄旭升, 周雅莉, 柴旭东, 闻婧, 王计平, 贾小云, 李润植. 紫苏质体型PfLPAT1B基因的克隆及其在油脂合成中的功能分析[J]. 生物技术通报, 2025, 41(7): 226-236. |
| [3] | 鲁天怡, 李爱朋, 费强. 生物合成聚乳酸研究进展[J]. 生物技术通报, 2025, 41(4): 47-60. |
| [4] | 魏敏华, 李晓童, 姜亚文, 周飘飘, 汪凯, 孙浩, 芦楠, 张成林. |
| [5] | 饶峻, 赵晨, 李端华, 廖豪, 黄加雨, 王辂. 自诱导策略在麦角硫因生物合成中的应用[J]. 生物技术通报, 2025, 41(1): 333-346. |
| [6] | 张静安, 胡孝龙, 曹蓓蓓, 廖敏, 束长龙, 张杰, 王奎, 操海群. 苏云金芽胞杆菌可视化快速表达载体的构建与特性分析[J]. 生物技术通报, 2025, 41(1): 95-102. |
| [7] | 何玙冰, 付振浩, 李仁瀚, 刘秀霞, 刘春立, 杨艳坤, 李业, 白仲虎. 利用代谢工程在酿酒酵母中高效合成2-萘乙醇[J]. 生物技术通报, 2024, 40(7): 99-107. |
| [8] | 张美玉, 赵玉斌, 王灵云, 宋元达, 赵新河, 任晓洁. 微藻破囊壶菌产功能性脂肪酸DHA研究进展[J]. 生物技术通报, 2024, 40(6): 81-94. |
| [9] | 王周, 余杰, 王金华, 王永泽, 赵筱. 厌氧表达乳酸脱氢酶以提高大肠杆菌产D-乳酸光学纯度[J]. 生物技术通报, 2024, 40(5): 290-299. |
| [10] | 庄棵, 梁至轩, 何英婷, 谢秋玲. 大肠杆菌DH5α通过外膜囊泡传递抗生素抗性基因AmpR[J]. 生物技术通报, 2024, 40(12): 275-281. |
| [11] | 何思成, 张紫瑗, 韩雨晴, 苗琳, 张翠英, 于爱群. 解脂耶氏酵母细胞工厂生产多不饱和脂肪酸的研究进展[J]. 生物技术通报, 2024, 40(1): 72-85. |
| [12] | 李亮, 徐姗姗, 姜艳军. 生物合成法生产麦角硫因的研究进展[J]. 生物技术通报, 2024, 40(1): 86-99. |
| [13] | 杨红艳, 韩筱, 杨建军. pDNA质粒在一次性生物反应器中的放大生产研究[J]. 生物技术通报, 2024, 40(1): 168-175. |
| [14] | 薛宁, 王瑾, 李世新, 刘叶, 程海娇, 张玥, 毛雨丰, 王猛. 多基因同步调控结合高通量筛选构建高产L-苯丙氨酸的谷氨酸棒杆菌工程菌株[J]. 生物技术通报, 2023, 39(9): 268-280. |
| [15] | 程亚楠, 张文聪, 周圆, 孙雪, 李玉, 李庆刚. 乳酸乳球菌生产2'-岩藻糖基乳糖的途径构建及发酵培养基优化[J]. 生物技术通报, 2023, 39(9): 84-96. |
| 阅读次数 | ||||||
|
全文 |
|
|||||
|
摘要 |
|
|||||